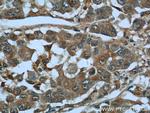
MAGEC2 Antibody in Immunohistochemistry (Paraffin) (IHC (P))

Search
Proteintech
MAGEC2 Polyclonal Antibody
{{$productOrderCtrl.translations['antibody.pdp.commerceCard.promotion.promotions']}}
{{$productOrderCtrl.translations['antibody.pdp.commerceCard.promotion.viewpromo']}}
{{$productOrderCtrl.translations['antibody.pdp.commerceCard.promotion.promocode']}}: {{promo.promoCode}} {{promo.promoTitle}} {{promo.promoDescription}}. {{$productOrderCtrl.translations['antibody.pdp.commerceCard.promotion.learnmore']}}
产品信息
10280-1-AP
种属反应
已发表种属
宿主/亚型
分类
类型
抗原
偶联物
形式
浓度
规格
纯化类型
保存液
内含物
保存条件
运输条件
产品详细信息
Immunogen sequence: SFSEESSSQ KGEDTGTCQG LPDSESSFTY TLDEKVAELV EFLLLKYEAE EPVTEAEMLM IVIKYKDYFP VILKRAREFM ELLFGLALIE VGPDHFCVFA NTVGLTDEGS DDEGMPENSL LIIILSVIFI KGNCASEEVI WEVLNAVGVY AGREHFVYGE PRELLTKVWV QGHYLEYREV PHSSPPYYEF LWGPRAHSES IKKKVLEFLA KLNNTVPSSF PSWYKDALKD VEERVQATID TADDATVMAS ESLSVMSS (111-367 aa encoded by BC005891)
靶标信息
MAGE-C2/C3 (Melanoma-associated antigen C2, Hepatocellular carcinoma-associated antigen 587) is a 373 amino acid protein encoded by the human gene MAGEC2. Genes of the MAGE family direct the expression of tumor antigens that are recognized on human melanomas by autologous cytolytic T lymphocytes. Among tumor tissues, MAGE-C2/C3 is frequently expressed in seminomas, melanomas, and bladder transitional cell carcinomas. It is also expressed in a significant fraction of head and neck carcinomas, breast carcinomas, nonsmall-cell lung carcinomas, and sarcomas. In hepatocellular carcinoma, there is a inverse correlation between tumor differentiation and protein expression, i. e. the lower the differentiation, the higher percentage of expression. MAGE-C2/C3 is not expressed in normal tissues, except in germ cells in the seminiferous tubules and in Purkinje cells of the cerebellum. It is strongly expressed in spermatogonia and primary spermatocytes, however, at later stages of maturation, expression gradually decreases to become undetectable in mature spermatids.
仅用于科研。不用于诊断过程。未经明确授权不得转售。
生物信息学
蛋白别名: Cancer/testis antigen 10; CT10; hepatocellular cancer antigen 587; Hepatocellular carcinoma-associated antigen 587; MAGE-C2; MAGE-C2 antigen; MAGE-E1 antigen; MAGEE1; melanoma antigen family C, 2; melanoma antigen family C2; melanoma antigen, family E, 1, cancer/testis specific; Melanoma-associated antigen C2; member of the MAGE protein family; unnamed protein product
基因别名: CT10; HCA587; MAGEC2; MAGEE1
UniProt ID: (Human) Q9UBF1
Entrez Gene ID: (Human) 51438